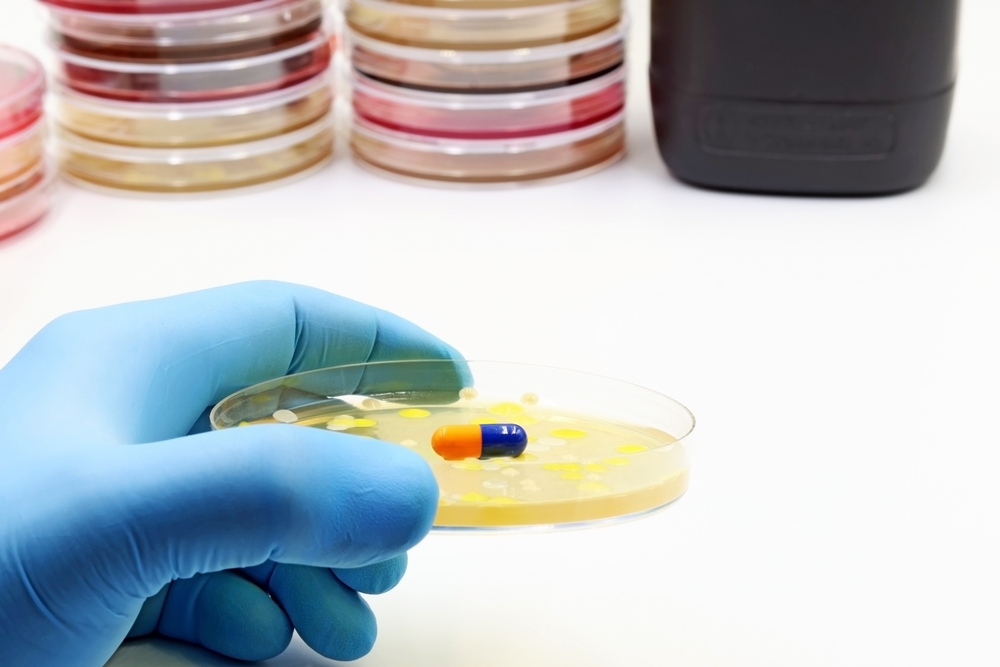

BIG_BIG_BEN
Μέγας
- Εγγρ.
- 28 Φεβ 2024
- Μηνύματα
- 7.193
- Like
- 11.897
- Πόντοι
- 3.556
Πολλή φασαρία κάνουν κάποιοι για τους υποτιθέμενους τούρμπο καρκίνους, που τους φαντάζει, ότι εξελίσσονται σε μάστιγα.
Δεν υπάρχουν όμως στοιχεία, που να επιβεβαιώνουν μια τέτοια τάση. Συχνά αυτοί οι ισχυρισμοί θεωρούνται παραπλανητικοί.
Έχετε εσείς γνωστούς, που να ατύχησαν, και να ασθένησαν σοβαρά κι απρόσμενα μες στα τελευταία δυο-τρία χρόνια;
Δεν υπάρχουν όμως στοιχεία, που να επιβεβαιώνουν μια τέτοια τάση. Συχνά αυτοί οι ισχυρισμοί θεωρούνται παραπλανητικοί.
Έχετε εσείς γνωστούς, που να ατύχησαν, και να ασθένησαν σοβαρά κι απρόσμενα μες στα τελευταία δυο-τρία χρόνια;